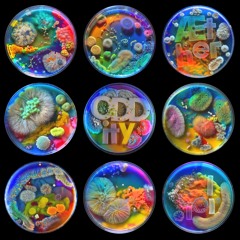

Rent
Moniker Prime
221
5:02
Feb 10, 2024
5
2
3
I made this track a couple of years ago and I remember, at the time, work was slow. I was struggling to have my rent on time. Driving for Uber, selling off music gear and other things I couldn't justify keeping, doing a …

![GENESIS [EP TEASER] - OUT NOW!](https://i1.sndcdn.com/artworks-IttPian4Nj2jCH8U-YudggA-t240x240.jpg)

